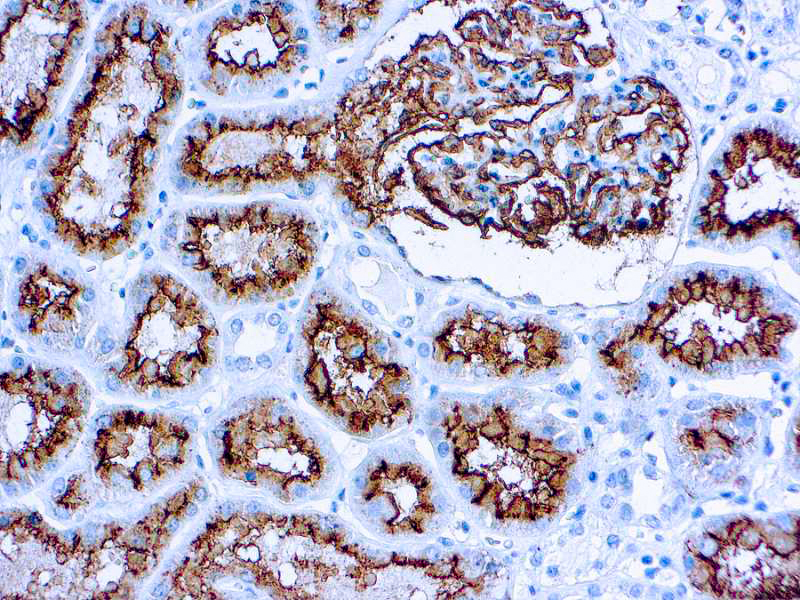

Recognizes a 100kDa glycoprotein, identified as CD10, also known as Common Acute Lymphocytic Leukemia Antigen (CALLA). It is a cell surface enzyme with neutral metalloendopeptidase activity, which inactivates a variety of biologically active peptides. CD10 is expressed on the cells of lymphoblastic, Burkitt’s, and follicular germinal center lymphomas, and on cells from patients with chronic myelocytic leukemia (CML). It is also expressed on the surface of normal early lymphoid progenitor cells, immature B cells within adult bone marrow and germinal center B cells within lymphoid tissue. CD10 is also present on breast myoepithelial cells, bile canaliculi, fibroblasts, with especially high expression on the brush border of kidney and gut epithelial cells.
CD10 CALLA
SKU: 8275
Categories: Primary Antibodies, IVD - For U.S. Market, IVD - Outside U.S. Market
Tags: Highlighter Product, HL72K-Core Kit, Concentrated, C
Description
Additional information
| Catalog No. | Mob240 Concentrated, PDM107 Prediluted |
|---|---|
| Clone | 56C6 |
| Isotype | IgG1 |
| Immunogen | Prokaryotic recombinant protein corresponding to the external domain of the CD10 glycoprotein. |
| Species | Mouse |
| Cellular Localization | cell membrane |
| Positive Control Tissue | Renal Cell Carcinoma, Tonsil |
| Pretreatment | EDTA Buffer pH 8.0 |
| Incubation & Temperature | 30 min @ RT |
| Intended Use | IVD |
| Detection System | PolyVue Plus – Two Step Detection System or Montage PolyVue Plus Auto Detection System for Montage 360 System |
| Description/Type | Mouse Monoclonal Antibody |
| Format | This product is supplied as a tissue culture supernatant and contains sodium azide as a preservative. |
DATASHEETS & SDS
DATASHEETS & SDS
| Download Datasheet |
| Download SDS Sheet – OSHA |
REFERENCES
REFERENCES
- Carrel et al. Melanoma Res 3: 319, 1993.
- Haralambidou et al. J Chin Pathol 40: 490, 1987.
- Kiyokawa et al. Clin Exp Immunol 79: 322, 1990.
- Scheuermann et al. Leukemia and Lymphoma 18: 385, 1995.
Reviews (0)
Only logged in customers who have purchased this product may leave a review.

Reviews
There are no reviews yet.